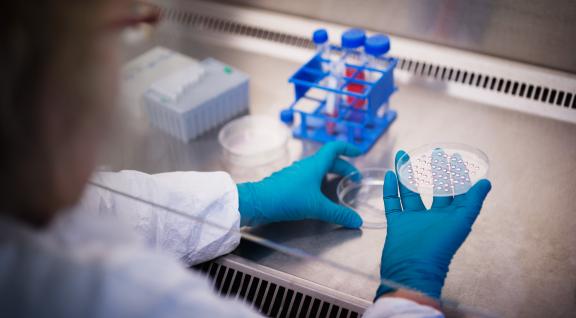
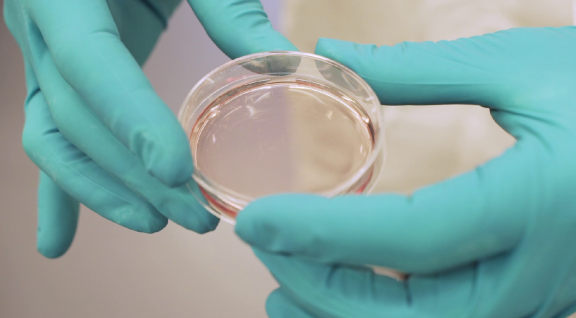
laborant bekijkt een petrischaaltje

Anne Kienhuis benoemd tot hoogleraar Toxicologie in Transitie aan Universiteit Utrecht
De Universiteit Utrecht heeft Anne Kienhuis, senior onderzoeker bij het RIVM, per 1 juni 2025 benoemd als hoogleraar Toxicologie in Transitie. Vanuit deze leerstoel draagt Kienhuis bij aan de verschillende ontwikkelingen in de toxicologie, waaronder de transitie naar proefdiervrije innovaties.

Proefdiervrij, Sophie Blommers